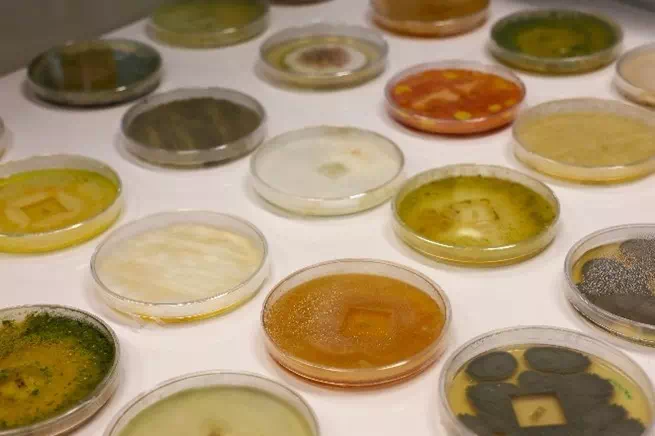

From 25-29 August 2025, the EDAPHOS and BIOSYSMO projects co-organised their first Summer School on Soil Remediation in Montbéliard, France. Over the course of five days, 20 participants, from students to early-career researchers, immersed themselves in lectures, fieldwork, and laboratory sessions dedicated to understanding and applying nature-based solutions for soil health and remediation.
The programme combined both projects’ innovative science approaches and research, with hands-on practice, providing a unique training experience.
Day 1 – Laying the Foundations
The Summer School opened with a series of expert lectures:
Dr. Nicolas Manier (INERIS) introduced participants to environmental risk assessment.
Dr. Aleksandra Zgorska, (GIG), introduced the students to ecosystem service evaluation.
Konstantinos Iordanoglou (CRES) presented findings from the GOLD Project on optimising lignocellulosic energy crops for phytoremediation.
Dr. Manhattan Lebrun & Dr. Humberto Castillo-Gonzalez (UMLP) explored phytoextraction through microbial optimisation and amendments.
Sophie Fabre (ONERA) closed the day with an introduction to remote sensing applications in environmental monitoring.
In the evening, participants discovered Montbéliard during a guided cultural visit, a perfect balance between scientific immersion and local exploration.
Day 2 – Exploring Ecotoxicity in the Lab
Workshops on the second day focused on methods for ecological and ecotoxicological risk assessment. Students measured soil enzyme activities (e.g. phosphatase) to better understand soil functions, and experimented with microfluidic devices to test contaminated soil leachates on nematodes.
In the afternoon, they turned to bioassays:
Daphnia magna, a model organism in ecotoxicology, was used to assess acute toxicity of environmental samples.
The Phytotoxkit microbiotest enabled students to evaluate seed germination and root growth in contaminated soils, in line with international standards (ISO 11269-1, OECD 208).
Together, these methods highlighted how animal and plant-based assays provide complementary insights for environmental risk assessments.



Day 3 – Parc des Alliaires Field Visit
Participants visited the Parc des Alliaires in Vieux-Charmont, where they observed both young poplar plantations and older trees planted to mitigate soil contamination. They practised species inventory, pigment measurement, and leaf sampling.
With sunny weather on their side, they also discovered how ONERA’s drones support remote sensing, offering innovative tools for monitoring contaminated soils from above. The footage captured during the field visits was analysed in the afternoon.


Day 4 – From Poplars to Physiology
Back in the field for this fourth day, the focus was on measuring young poplars: height, stem diameter, and chlorophyll content using chlorophyll content meters (CCM). These indicators are essential to evaluate plant vitality and stress, connecting physiological measurements with ecological outcomes.
Later in the lab, students split into two groups:
Fungal Strains for Phytoremediation: Practising fungal isolation and characterisation to explore microbial support for remediation.
Plant Health Monitoring: Using stomatal conductance and other physiological parameters to assess plant stress and proper functioning.
These sessions deepened their understanding of how both plants and microbes contribute to soil restoration strategies.

Day 5 – Wrapping Up
The final day provided time to consolidate knowledge, exchange insights, and reflect on the connections between field observations, lab experiments, and broader soil health strategies.
Final conclusions
Over five days, the Summer School combined classroom lectures, laboratory experimentation, and field visits to offer a holistic view of soil remediation challenges and opportunities.
We warmly thank all participants, whose enthusiasm and engagement made this event such a success, and our speakers and instructors, who shared their expertise with passion.
EDAPHOS & BIOSYSMO
Sponsored by: Harmi and TRANSBIO Graduate School.